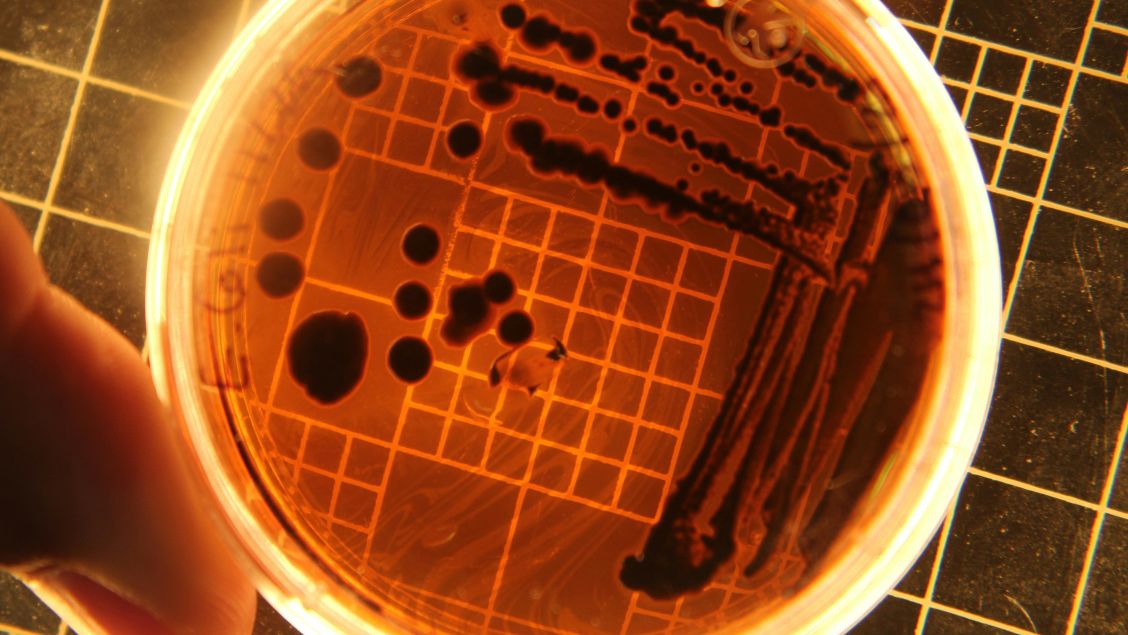

Interview With Our Specialist English Editors
Specialist editing is a professional service that goes beyond proofreading authors’ research. It is tailored to authors’ needs and delivered by subject specialists with expertise in the author’s field of study. Thus, researchers receive invaluable feedback on the content of their paper, as well as a comprehensive report with a detailed analysis of strengths and weaknesses.
MDPI Author Services offers language and specialist editing services to all researchers. We interviewed three of our PhD-qualified Specialist English Editors—Lauren, Neha, and Jemima—to discuss the importance of specialist editing and their roles in the department.
What does the Specialist Editing process entail?
Specialist Editing is a really thorough process in which PhD-qualified editors with an in-depth knowledge of a particular subject area critically analyse a manuscript for its scientific content and structure.
This edit does not focus on the language of the paper (which is addressed at a later stage by MDPI’s English Editors), but rather it assesses the structure of a manuscript; whether any information is missing or misreported; and if the paper would benefit from any further or more in-depth discussions.
A comprehensive report is also given to the authors. This gives more extensive details on the comments and feedback of a paper and how and why the authors should address them.
What sets this service apart from others?
The service that MDPI offers is a rigorous one. The edit is carried out by a subject-specific specialist who is able to provide suggestions and feedback that are highly relevant to the authors’ field of expertise. This results in the comments being decidedly reliable and of a high quality.
The Academic Report that is provided as part of the service is assuredly detailed, allowing authors to not only implement the changes suggested, but to understand why they should be made. This encourages them to apply these ideas to all the future papers they may publish.
What are the advantages of having your research professionally edited prior to submission?
Following a specialist edit, a manuscript will be of exceedingly high quality, in terms of both the structure and content. These advantages will put the paper in great stead for achieving high visibility and impact, increasing the reach of the author’s work.
What do you enjoy most about your position as a Specialist English Editor?
As a Specialist English Editor, I most enjoy being able to incorporate my background and experience in chemistry and pharmacy with my role as an editor. Advising authors and providing them with feedback to improve their manuscripts gives me a sense of pride, knowing that their research will be put out into the world at a top-quality standard.
What does a typical day look like in your role as a Specialist English Editor?
Specialist editing is a premium service offered by MDPI. Thus, I prioritise these edits over other work tasks on a given day.
Most of my workday mornings are spent working on specialist edits. Each day, the Author Services team informs all Specialist English Editors of the numerous available specialist edits, and I express my interest to the Author Services team to receive a specialist edit that I wish to edit.
Notably, the Author Services team assigns a specialist edit only to a Specialist English Editor who has a relevant PhD in the subject of the manuscript rather than on a first-come-first-serve basis. This ensures that the edit is performed by a Specialist English Editor with the most relevant knowledge from the team, thereby providing the client with a high-quality deliverable.
What is the difference between language editing and specialist editing?
Language editing ensures that a manuscript is clear, consistent, and grammatically correct and also that the manuscript complies with the MDPI house rules if the manuscript’s target journal is an MDPI journal.
However, specialist editing is performed after a thorough language edit has already been performed. A Specialist English Editor ensures that the structure, flow, and field-specific language and terminology are appropriate and makes the necessary corrections, which are not within the remit of a language edit and are more invasive.
Furthermore, a Specialist English Editor assesses whether a manuscript has all the required information and is well written, well structured, and well referenced. The Specialist English Editor also advises the authors on ways to improve their manuscript in terms of clearly communicating the rationale and results of their study or filling missing content gaps in the manuscript, especially where the changes entail missing information that can included only by the authors.
These improvements are conveyed by a Specialist English Editor through appropriate comments in the manuscript and the Specialist English Editor’s Report.
What is included in the Specialist English Editor’s Report?
The Specialist English Editor’s Report provides a summary of all the aspects of a manuscript that are assessed by a Specialist English Editor, to ensure that the manuscript is presented in the best possible manner to its readers.
It informs the authors of the parts of the manuscript that were already apt, the improvements that were made by the Specialist English Editor, and any additional information that the authors need to include to enhance the quality of their manuscript. The report provides an overview of the assessment of the title, structure, flow, usage of abbreviations/acronyms, figures, tables, references, quotations, field-specific terminology and language, novelty, and possible ethical issues of a manuscript.
Moreover, it provides feedback on each individual section of the manuscript from the Abstract to Conclusion, ensuring that the authors have a clear idea of what changes have been suggested and what needs to be done to bring their manuscript to publishable standards.
How do editing services support the academic community more broadly?
High-quality research is conducted around the globe, in countries that speak English and ones that do not. However, English is the most predominant language used to communicate science, and most high Impact Factor journals are published in the English language.
Thus, researchers, especially the ones who are non-native English speakers, may require some assistance in communicating their research in clear, consistent, and grammatically correct English. This is where the editing services support and facilitate the academic publishing process, providing researchers with the confidence to pitch their papers to and publish them in the best possible journal.
Thus, editing services aid the academic community in communicating its research to a large readership, enhancing the utilization and application of the research.
What drew you to MDPI and a career in academic editing?
After nearly a decade in academia, I felt I wanted to shift focus and apply my skills in a more fast-paced and impact-driven environment and MDPI felt like a perfect fit. With its global reach and commitment to open access publishing, MDPI’s ethos firmly aligns with my own: knowledge should be shared and academia should be as inclusive as possible.
How do you and the department balance quality with efficiency during the editing process?
As someone who works primarily in the Quality Control Department, I know that this balancing act is something that we are continuously perfecting. Quality and efficiency are two of the central tenets of the English Department as a whole. Our Editors, including Specialist English Editors, are continuously monitored against these two measures, ensuring an excellent and uniform standard across the department. As such, authors can rest assured that their research is in the best possible hands.
As Specialist English Editors more specifically, our feedback methods mean that our processes are streamlined, and authors receive their report quickly and efficiently without compromising quality.
How do authors benefit from the Specialist Service?
With our Specialist Editing Service, you receive detailed, tailored feedback from an Editor with both English language expertise and subject-specific knowledge. Having these valuable, expert eyes review your work can help decrease the chances that your manuscript(s) will be sent back for revisions, as mistakes and areas for improvement can be caught and flagged quickly, saving time and limiting stress.
What are the advantages of using our editing services over artificial intelligence (AI) tools?
The Editors working as part of the Specialist Editing Service have specialist knowledge, including a thorough understanding of the intricacies of their various fields and the relevant audiences. As employees of one of the largest and most prolific open access academic publishers, Specialist English Editors at MDPI also have an excellent understanding of the academic publishing process.
AI tools are no match for years of dedication in academia and extensive professional publishing experience. What’s more, AI writing and editing aids can often miss more subtle errors in your writing; at worst, they can leave obvious mistakes and tortured phrasing, and such mistakes can undermine your research and hinder its reach. As fellow scholars, we understand that weeks, months, and years of hard work and expertise have gone into the manuscripts we receive for editing, and this is why we treat them with meticulous care.
If you want to learn more on this topic, read our previous article The Benefits of Specialist Editing.
If you want to prepare your research for publication, MDPI Author Services offers high-quality specialist editing by PhD specialists in your field. This service offers a detailed report compiled by the Specialist English Editor, reviewing each section in detail as well as structure, terminology, and more.
Our team of highly skilled English editors have edited over 60,000 papers, with a 97% author satisfaction rate. Our services are available to both MDPI authors and those publishing with other journals. Visit the link above to get a free quote today.

This interview with academic editors offers valuable insights into the publishing process! I especially appreciate the tips on improving manuscript quality and navigating peer review. A must-read for anyone looking to refine their academic writing.
Thank you for your comment,
All the best.